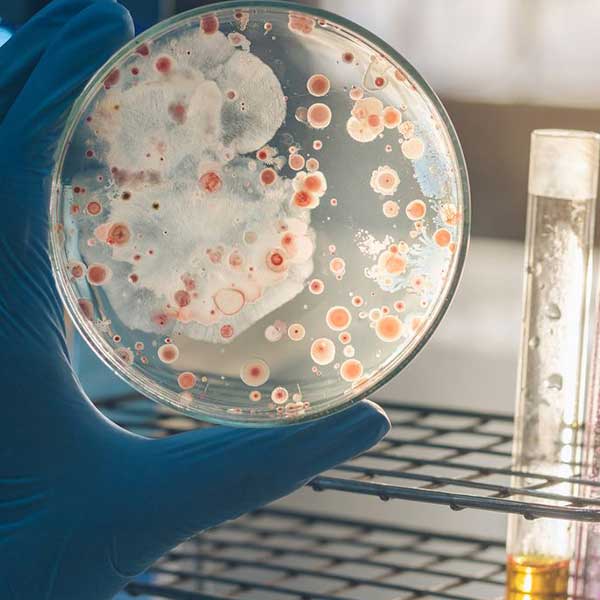

Opening Hours
Doctors TimeTable
Omega Diagnostics allows you to have a consultation with doctors. You can book the appointment in between 6.30 pm to 9.00 pm from Monday to Saturday.
appointments
For any tests or ECG, you may fix an appointment at Omega. Contact us 24/7 for your clinical needs and diagnostics solutions. Call us or fill the contact form to make us get back to you.
Why choose Omega?
Qualified Specialists
All our lab technicians make all the efforts to deliver comprehensive diagnostic services
Robust Equipment
We render error-free diagnostic reports because of our advanced equipment
Free Home Sample Collection
We make things easier for you. Our staff will collect your sample at your doorstep.
All Kinds
of Diagnostics
Omega provides a one-stop solution to all your health assessment needs. From blood tests to MRI, we provide everything!
Our Services
Omega provides an exhaustive range of diagnostic services. We use modernized equipment to increase convenience, ease, and quick delivery of the test reports.
Testimonials
Excellent service , they are using advanced technology i get a report quickly in less cost .
Excellent centre, quick service, all the best for team
Timely Diagnosis Delivered
The right diagnosis at the right time will help you respond quickly and alleviate your health issues